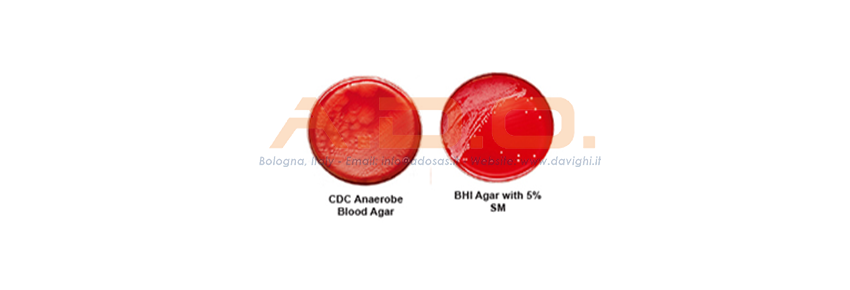
Ready-to-use plates

BECTON DICKIN
Products, Solutions and Services for Clinical Microbiology and Industry.

Security policy (edit with Customer reassurance module)
Delivery policy (edit with Customer reassurance module)
Return policy (edit with Customer reassurance module)
The objective of Becton Dickinson is to support the practice of the Microbiology Laboratory at every stage of the production process, sample collection to the useful and active management of information, providing the experience of men, the history and products of a Leades company in the research and development of microbiological diagnostics. Never forget the last end: The centrality of the Microbiology Laboratory for a timely, effective and efficient, patient therapy.
A.D.O. MEDICAL is the official dealer of laboratory products of the company Becton Dickinson.
NB:
FOR RESEARCH WITH CODE AND/OR DESCRIPTION:

BECTON DICKIN
Products, Solutions and Services for Clinical Microbiology and Industry.